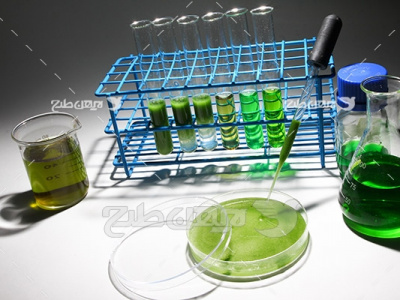

برچسب رف
تعداد 1257 آيتم در آرشيو
بر اساس نوع:

طرح لایه باز فاکتور فروش59000 تومان


پنل خورشیدی رایگان

لوازم آزمایشگاه رایگان


عکس صنعتی رایگان


عکس با کیفیت از لامپ و بوکه نور رایگان


لامپ آژیر قرمز پلیس و خطر و اعلام... رایگان


لامپ آژیر قرمز پلیس و خطر و اعلام... رایگان


لامپ آژیر قرمز پلیس و خطر و اعلام... رایگان


عکس لامپ و الکتریکی رایگان


عکس لامپ رایگان


لامپ رایگان


عکس لامپ و آب رایگان


عکس با کیفیت از لامپ رایگان


عکس لامپ و الکتریکی رایگان


عکس لامپ رایگان


لامپ رایگان


عکس لامپ رایگان


عکس با کیفیت از لامپ و بدن انسان رایگان


عکس لامپ و الکتریکی رایگان


عکس لامپ رایگان
